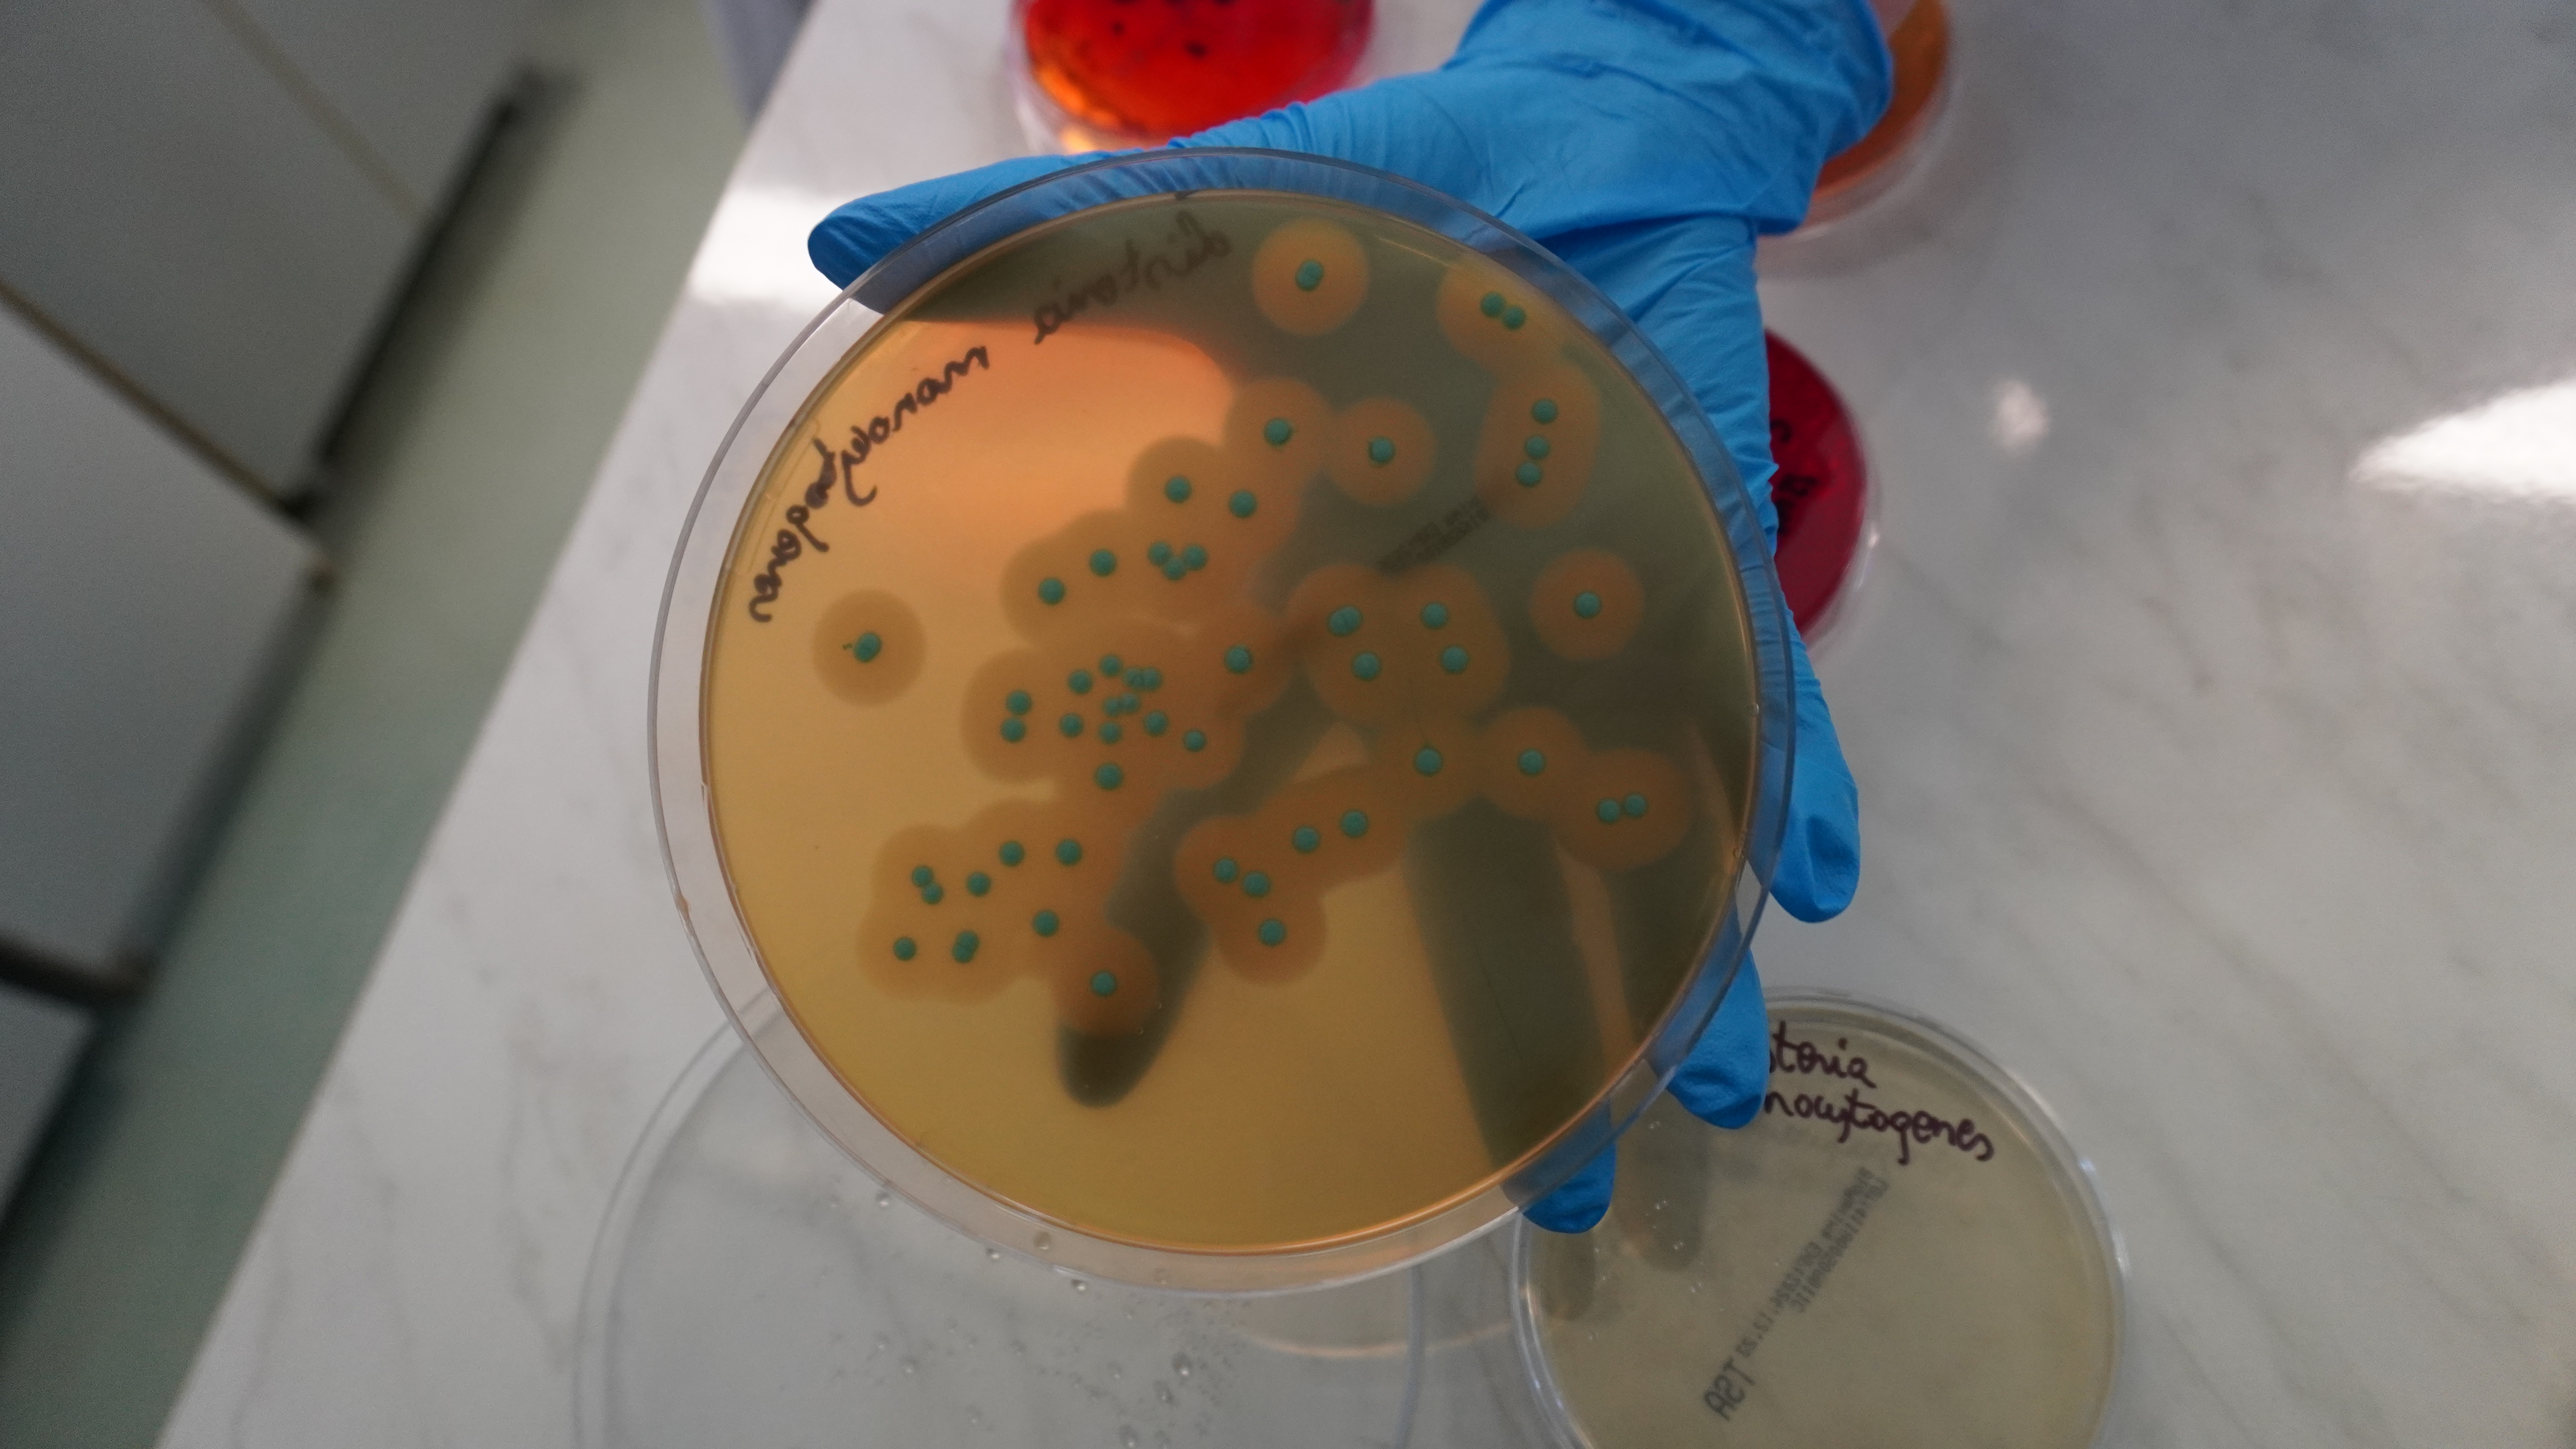

Wizyta Studentów Technologii Żywności i Żywienia Człowieka w Laboratorium WSSE w Szczecinie
06.02.2025

Studenci V roku Technologii Żywności i Żywienia Człowieka z Zachodniopomorskiego Uniwersytetu Technologicznego mieli ostatnio okazję odwiedzić laboratorium Wojewódzkiej Stacji Sanitarno-Epidemiologicznej w Szczecinie. Podczas wizyty zapoznali się z najnowocześniejszymi metodami badania jakości żywności, wody do spożycia, a także dowiedzieli się, jak przeprowadza się analizę mikrobiologiczną oraz mieli okazję porozmawiać z doświadczonymi specjalistami w tej dziedzinie.
Mamy nadzieję, że to doświadczenie pozwoliło studentom zobaczyć, jak teoria przekłada się na praktykę i zainspiruje ich do dalszego zgłębiania wiedzy w zakresie bezpieczeństwa żywności.